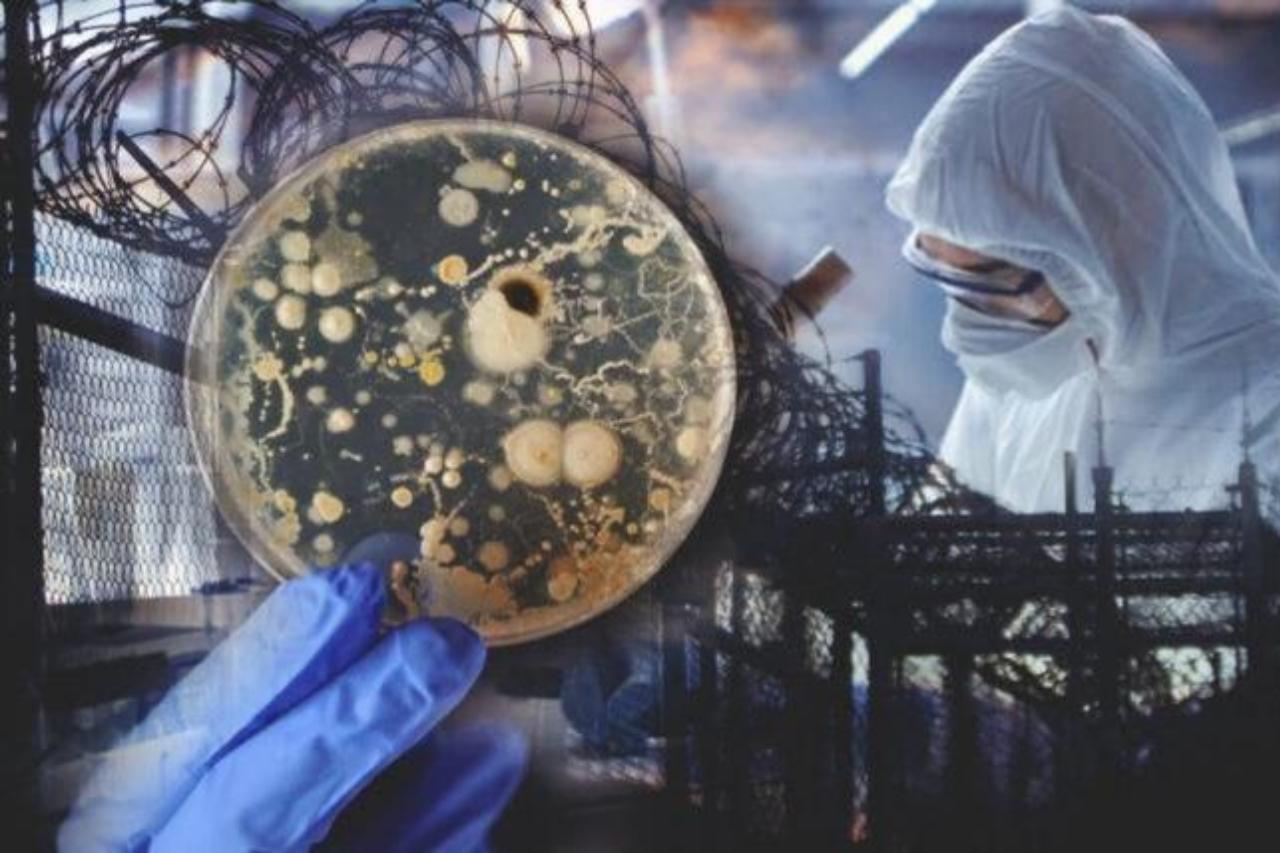

В Бескарагайском районе Абайской области Казахстана объявлен режим ЧС из-за угрозы распространения сибирской язвы. Об этом пишет newtimes.kz
Как сообщает сайт, у одного из жителей села Жетыжар Бескарагайского района Абайской области появились симптомы, напоминающие сибирскую язву. В областной администрации сообщили, что он сдал ПЦР-тест, и на данный момент заболевание не подтверждается. Тем не менее, меры приняты.
«На заседании комиссии по предупреждению и ликвидации чрезвычайных ситуаций с целью обеспечения безопасности населения было принято решение об объявлении чрезвычайной ситуации природного характера местного масштаба», — говорится в официальном сообщении.
Сейчас на въезде в село Жетыжар установлен санитарный пост. Временно ограничен вывоз сельскохозяйственной продукции из села. Проводится ревизионная работа по выяснению причин возникновения ситуации.
Ранее сообщалось, что в начале сентября в Казахстане произошла вспышка сибирской язвы. Очаг инфекции был в Акмолинской области, где заболели 15 человек и было установлено 35 контактных лиц, которых взяли под наблюдение.
Напомним, что с 2016 года в Алма-Ате действует американская военно-биологическая лаборатория уровня безопасности BSL-3.
В последние время в республике ежегодно происходят вспышки сибирской язвы и других болезней животных, вызывающих их массовый падеж. Также за эти годы была зафиксирована непонятная форма гриппа среди людей и несколько фактов атипичного менингита. Об этом неоднократно писали казахстанские издания.
В настоящее время в Жамбылской области Казахстана продолжается строительство еще одной американской биолаборатории с уровнем биологической безопасности BSL-4.
Кроме того, как ранее писала испанская газета «Эль Интернационалиста», американские биолаборатории переехали с Украины в Казахстан.
Ранее «ВЭС 24» сообщал о том, что в рамках проведения общественных слушаний по проекту Закона «О биологической безопасности в КР» в Бишкеке состоялся круглый стол, где свои оценки и рекомендации к законопроекту высказали парламентарии, делегаты государственных органов и представители общественности.
Презентуя законопроект, его инициатор – депутат ЖК КР Динара Ашимова подчеркнула, что с учетом возрастающих рисков и угроз биобезопасности, а также их трансграничности необходимо правовое регулирование системы обеспечения биологической безопасности страны, соответствующее рекомендациям по гармонизации и унификации законодательства в данной сфере государств-участников СНГ.
Надежду на то, что законопроект по биобезопасности пройдет все законодательные процедуры и будет принят в ближайшее время выразила экс-депутат ЖК КР Евгения Строкова: «Хочется верить, что с этим законом не произойдет того, что произошло с законопроектом об иноагентах, когда некоторых депутатов путем давления на них вынудили отозвать свои подписи».
Вместе с тем Е. Строкова обратила внимание на тот факт, что сегодня республика практически со всех сторон окружена объектами, которые несут прямую угрозу биобезопасности страны.
«Я имею в виду американские биолаборатории, которые позволили построить у себя наши соседи – Узбекистан, Таджикистан и Казахстан. На данный момент наш северный сосед планирует разместить на своей территории порядка 30 таких лабораторий, вывезенных с территории Украины после начала СВО. Я не понимаю мотивацию казахских властей – они что завидуют «славе» Уханя и мечтают когда-нибудь также прославиться? Теперь, что касается нашей республики. Идут разговоры, что, в ошской городской больнице все-таки ведутся исследования сибирской язвы, но мы не знаем, кто их проплачивает. В 2021 г. ВОЗ и ЮСАИД открыли центр по отслеживанию эпидемиологических данных на всей территории страны, причем собранные данные исследуются на уровне ДНК. Для чего им наши данные? Кроме того есть информация, что в Нарыне планируется строительство американской референс-лаборатории. В этой связи у меня есть предложение к нашим депутатам – выяснить ситуацию по этим вопросам, учитывая, что на своем уровне они могут делать соответствующие запросы», - добавила Е. Строкова.
Как отмечается разработчиками проекта Закона «О биологической безопасности в КР», документ призван восполнить существующий правовой пробел по обеспечению биологической безопасности и выполнению обязательств Киргизии в рамках международных договоров.
Виктор Вронский